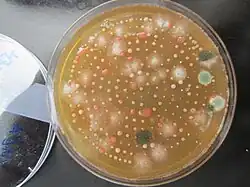

Luftkeimsammlung
Die Luftkeimsammlung ist eine Methode zur Bestimmung der kultivierbaren luftgetragenen Schimmelpilzsporen in der Raumluft. Neben anderen Verfahren wie der Partikelsammlung, die der Bestimmung der Gesamtsporenkonzentration dient, und der MVOC-Messung (MVOC = microbial volatile organic compounds), mit der flüchtige Stoffwechselprodukte nachgewiesen werden können, ist die Luftkeimsammlung eine von mehreren Möglichkeiten, die Raumluft auf Schimmelpilzbelastungen zu untersuchen. Sie dient dazu, über die Sammlung eines definierten Luftvolumens auf Nährmedien oder Filter Hinweise auf verdeckte Innenraumschimmelquellen aufzuzeigen. Seltener wird sie noch herangezogen, um den Erfolg von Sanierungen zu kontrollieren, da die Luftkeimsammlung hierfür nur sehr bedingt geeignet ist[1] (siehe unten).
Die Luftkeimsammlung ist eine sehr weit verbreitete Methode zur Untersuchung der Raumluft. Zu unterscheiden ist das Sammeln von Schimmelpilzsporen aus der Luft durch Filtration oder durch Impaktion. In beiden Verfahren wird eine definierte Menge Luft mithilfe einer Pumpe angesaugt und die in der Luft enthaltenen Schimmelpilzsporen auf einem Filter (Filtration) oder direkt auf dem Nährmedium (Impaktion) abgeschieden[2]. Verbreiteter und bekannter ist das Impaktionsverfahren. Auf dieses beziehen sich in der Regel die Aussagen über Luftkeimsammlungen. Nicht zu verwechseln ist eine solche Luftkeimsammlung mit einer „Do-It-Yourself-Messung“, bei der für eine bestimmte Zeit Petrischalen mit einer Nähragarlösung aufgestellt und anschließend die darauf sedimentierten Sporen angezüchtet und untersucht werden. Da sie in der Regel nicht reproduzierbar sind, sind die Ergebnisse solcher DIY-Kits nicht belastbar[2].
Vorbereitung
Vor der Innenraummessung darf der zu untersuchende Bereich mindestens acht Stunden nicht mehr gelüftet werden, um das aktuelle Spektrum der Keime im Innenraum nicht durch die Außenluft zu stark zu beeinflussen. Ein besonderes Augenmerk sollte auch auf der Terminwahl liegen, wenn eine Außenluftprobe als Referenz dienen soll, da die natürliche Sporenbelastung stark von den örtlichen Wetterbedingungen beeinflusst wird.
Durchführung
Um einem möglichst breiten Artenspektrum ein geeignetes Substrat zu bieten, werden mehrere verschiedene Nährmedien je Messpunkt verwendet. Verwendet werden üblicherweise Malzextrakt-Agar und DG18-Agar für Schimmelpilze. Sollen auch Bakterien untersucht werden, kommt CASO-Agar infrage[1]. Die Nährmedien werden in Petrischalen in das Probenahmesystem eingelegt, das die Luft kontrolliert einsaugt und gleichmäßig über die gesamte Nährmedienfläche verteilt. In der Regel wird parallel zu der Luftkeimmessung im zu untersuchenden Raum auch eine Probe von der Außenluft als Referenzwert für die Bewertung mit herangezogen, um zwischen natürlicher Schimmelpilzbelastung und möglichem Schimmelbefall unterscheiden zu können. In einigen Fällen macht es aber Sinn, statt der Außenluftprobe einen anderen Raum ohne Schimmelbefall als Referenz zu wählen, beispielsweise, wenn eine Außenluftbeeinflussung nicht zu erwarten ist. Auch ist das Keimspektrum stark jahreszeit- und temperaturabhängig.
Ist nach Kultivierung der Agarplatten eine untypische Veränderung auszumachen, so deutet dies auf eine Innenraumquelle hin. Dies wäre zum Beispiel dann der Fall, wenn die Proben aus dem untersuchten Raum eine deutlich größere Belastung aufweisen, als die Refenzprobe, oder Sporen vertreten sind, die sich zum Messzeitpunkt in der Außenluft nicht nachweisen ließen.
Aussagekraft
Der große Vorteil der Luftkeimsammlung gegenüber den beiden oben genannten anderen Verfahren ist, dass sich die so entdeckten Schimmelpilze sehr viel genauer, oft bis auf Artenebene bestimmen lassen. Dies ermöglicht zum einen eine detailliertere Einschätzung des Gefahrenpotentials (zum Beispiel durch Einordnung in Risikogruppen). Zum anderen gibt die Artenverteilung gegebenenfalls Hinweise, die bei der Lokalisierung und Einschätzung des Schadens helfen.
Grundsätzlich zu beachten ist, dass so eine Raumluftuntersuchung eine Momentaufnahme ist. Die Sporenbelastung, sowohl in der Natur als auch im Falle eines Schimmelpilzbefalls im Innenraum, unterliegt oft erheblichen Schwankungen, sowohl in Bezug auf das Vorkommen als auch auf die Sporenverteilung. Sie ist stark abhängig von Größe und Form der jeweiligen Sporen (Flugeigenschaften!) sowie Luftzirkulation, Bewegung im Raum, Feuchtigkeit, Staublast. Der Nachteil der Methode ist, dass sich viele Schimmelpilzarten hiermit kaum oder gar nicht nachweisen lassen. Dies liegt zum einen daran, dass die Sporen durch die Probenahme unter Stress gesetzt werden und dadurch die Keimfähigkeit abnimmt[2]. Einige Sporen lassen sich generell auf den üblichen Nährmedien nicht anzüchten. Andere wachsen eher langsam und werden von anderen Kolonien in ihrem Wachstum gehemmt oder überwuchert. Wieder andere haben derart schlechte Flugeigenschaften, dass die Wahrscheinlichkeit, dass sie von dem Probenahmegerät aus der Luft aufgenommen werden können, äußerst gering ist. Zur letzten Gruppe zählen unter anderem typische Indikatorpilze für Feuchteschäden wie Stachybotrys, Chaetomium und Acremonium[3], die auch Mykotoxine bilden. Besonders bei verdeckten Schäden kann es deshalb vorkommen, dass trotz umfangreichen Befalls nur unauffällige Schimmelpilzkonzentrationen in der Raumluft nachweisbar sind. Bei hoher Sporenbelastung kann es andererseits passieren, dass die Schimmelpilzkolonien auf den Nährböden ineinanderwachsen. So wird eine quantitative Auswertung unmöglich[1].
Aus den vorgenannten Gründen ist die Aussagekraft der Luftkeimsammlung für sich alleine betrachtet sehr begrenzt, wohl aber kann sie in Kombination mit anderen Verfahren hilfreich sein. Eine parallel ausgeführte Partikelsammlung zwecks Bestimmung der Gesamtsporenkonzentration kann die Ergebnisse der Luftkeimsammlung in ein repräsentatives Gesamtbild rücken. Verfahren wie die Partikelmessung, die ohne das Anzüchten der Proben auskommt, wurden entwickelt, gerade weil in der Regel nur ein Teil der tatsächlich vorhandenen Schimmelpilzsporen anzüchtbar ist, andererseits allergische oder toxische Wirkungen auch von nicht kultivierbaren Mikroorganismen und deren Bestandteilen ausgehen können[2].
Ohne ergänzende Messverfahren ist die Luftkeimsammlung als Sanierungskontrolle ungeeignet. Derzeit setzt sich die von der WTA vorgeschlagene Vorgehensweise als allgemein anerkannte Regel der Technik durch, insbesondere seit auch der Schimmelleitfaden des Umweltbundesamtes auf das entsprechende Merkblatt[4] verweist. Hierbei ist die Bestimmung der Gesamtsporenbelastung das Verfahren der Wahl. Zudem findet eine Mobilisierung statt, bei der sedimentierte Partikel gezielt aufgewirbelt werden.
Einzelnachweise
- ↑ a b c Judith Meider: Schimmelpilzanalytik: Grundlagen, Methoden, Beispiele. 1. Auflage. Rudolph Müller, Köln 2016, ISBN 978-3-481-03374-3, S. 80,88.
- ↑ a b c d Innenraumlufthygiene-Kommission des Umweltbundesamtes (Hrsg.): Leitfaden zur Vorbeugung, Erfassung und Sanierung von Schimmelbefall in Gebäuden. 2017, ISSN 2363-8311, S. 21,95,101–102.
- ↑ Manfred Hinker, Martina Seibert (Hrsg.): Pilze in Innenräumen und am Arbeitsplatz. Springer Verlag Wien, Wien 2013, ISBN 978-3-7091-1234-2, S. 209.
- ↑ Wissenschaftlich-Technische Arbeitsgemeinschaft für Bauwerkserhaltung und Denkmalpflege e.V. (Hrsg.): Ziele und Kontrolle von Schimmelpilzschadenssanierungen in Innenräumen. Fraunhofer IRB, November 2016.